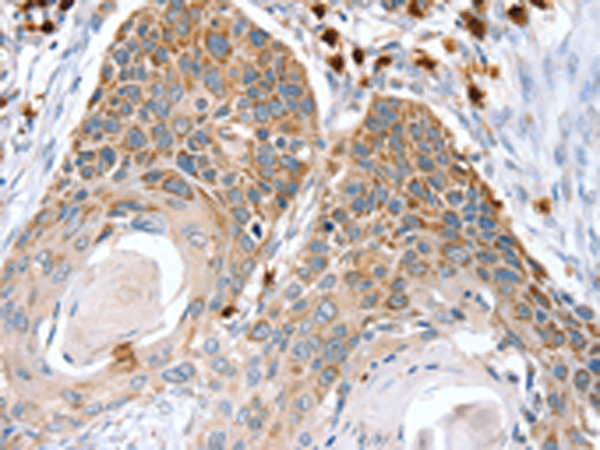
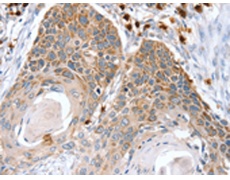
一抗

中文名稱:兔抗RNF185多克隆抗體
英文名稱: Anti-RNF185 rabbit polyclonal antibody
相關(guān)類別: 一抗
儲 存: 冷凍(-20℃)
宿 主: Rabbit
抗 原: RNF185
反應(yīng)種屬: Human, Mouse, Rat
標(biāo)記物: Unconjugate
克隆類型: rabbit polyclonal
技術(shù)規(guī)格
|
Background: |
RNF185 (ring finger protein 185), also known as FLJ38628, is a 192 amino acid multi-pass membrane protein containing one RING-type zinc finger. Two RNF185 isoforms exist as a result of alternative splicing, and the gene encoding RNF185 maps to human chromosome 22, which houses over 500 genes and is the second smallest human chromosome. Mutations in several of the genes that map to chromosome 22 are involved in the development of Phelan-McDermid syndrome, Neurofibromatosis type 2, autism and schizophrenia. |
|
Applications: |
ELISA, IHC |
|
Name of antibody: |
RNF185 |
|
Immunogen: |
Fusion protein of human RNF185 |
|
Full name: |
ring finger protein 185 |
|
SwissProt: |
Q96GF1 |
|
ELISA Recommended dilution: |
1000-2000 |
|
IHC positive control: |
Human esophagus cancer |
|
IHC Recommend dilution: |
10-50 |
購物車
購物車 幫助
幫助
 021-54845833/15800441009
021-54845833/15800441009